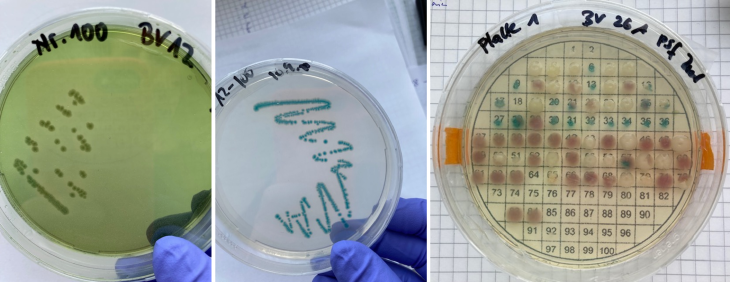
fdhg

2021 BaltVib field survey
The main aim of the BaltVib field survey in July/August 2021 was to analyse the current pelagic and benthic composition of the microbiological community with special focus of Vibrio bacteria within and outside of eelgrass meadows, mussel beds and selected macroalgae populations in the salinity gradient of shallow coastal waters of the Baltic Sea. Vibrio occurrence will be related to abiotic and biotic environmental factors.

Study area
Sampling was carried out in territorial waters of Denmark, Germany, Sweden, Poland, Lithuania, Estonia, and Finland across a mesohaline salinity gradient. A total of 22 stations were sampled for microbiological community composition, hydrophysical and hydrochemical environmental factors as well as for habitat structure of eelgrass meadows and macroalgae habitats, respectively. Each station was divided into three sub-stations. One located within the target habitat (Zostera marina, Ruppia maritima, Fucus vesiculosus, Potamogeton sp., Characeae, Mytilus sp.), one app. 15 m upstream from the target habitat, one control station without vegetation. Due to the limited depth distribution of the target habitats, stations were located in a depth range of 1-10 m less than 1 nm from the shore.

Sampling was done during two field campaigns this summer: stations in Poland, Lithuania, Denmark, Sweden and some of the German stations were approached from land with small working boats; stations in Estonia, Finland and some of the German stations were approached by R/V Elisabeth Mann Borgese during the research cruise EMB283. During the cruise, the working boat Klaashahn was deployed from R/V Elisabeth Mann Borgese to reach the very shallow stations. Generally, a research diving group from IOW or from partner institutes took all the biological and hydrochemical samples.



The research diving group from the BaltVib partner Estonian University of Life Sciences joint our sampling campaign close to Saaremaa island. Joint sampling of the German and Estonian groups aimed to harmonize the sampling procedure (Photos: ©Kube/IOW)


Parameters and methods
A variety of environmental parameters were determined at each sub-station 20 cm above the seafloor: temperature, salinity, pH, dissolved oxygen, water transparency, nutrients (ammonium, nitrate, phosphate, silicate), chlorophyll a, organic carbon and organic nitrogen, chitin, phytoplankton and zooplankton. The abundance of eelgrass and macroalgae as well as the length of eelgrass leaves were determined by counting plants/algae in defined areas within eelgrass/macroalgae meadows by divers. For DNA analyses of the microbiological community water samples, sediment samples and samples of eelgrass/macroalgae biofilms were taken by divers.
Water samples for nutrient analyses, organic carbon and organic nitrogen analyses, chlorophyll a, chitin, DNA and RNA analyses were filtrated and stored in a deep freezer directly after sampling. Sediment samples as well as samples from eelgrass and macroalgae were treated ultrasonic to remove the microbial biofilm community and prepared and stored for later DNA analyses. Phytoplankton samples were fixed with Lugol and stored at room temperature for later analyses of the phytoplankton species composition. Zooplankton samples were fixed in 4% buffered formaldehyde and stored for later zooplankton species composition.
Water samples, sediment samples and biofilm samples were plated on TCBS and chrom-agar for bacterial cultivation.